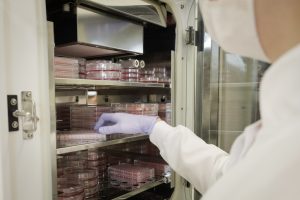

Núcleo Vitro: excelência em pesquisa e especialistas em soluções com inovação científica
Somos movidos pelo amor a ciência, dedicação às pessoas e compromisso com qualidade, agilidade e confiança.

MISSÃO:
Impulsionar a inovação científica conectando ciência aplicada às necessidades reais das empresas e pessoas;
VISÃO:
Ser referência em inovação científica e em biotecnologia no Brasil;
VALORES:
Amor pela ciência: Acreditamos na ciência como ferramenta de transformação e colocamos paixão em cada estudo realizado.
Qualidade, agilidade e confiança nas relações: Nos comprometemos com altos padrões de excelência, entregas rápidas e relações transparentes, cultivando parcerias de longo prazo.
Olhar atento, inovador e estratégico: Observamos o presente com profundidade e antecipamos o futuro com criatividade e visão, conectando ciência, mercado e impacto em cada decisão.
Presença em empresas no Brasil e 12 países diferentes

Inovação que redefine limites!
Bem-vindo à Núcleo Vitro, onde a excelência científica encontra a inovação com uma equipe dedicada, formada exclusivamente por mulheres apaixonadas pelo avanço da ciência. Nosso compromisso é ir além, desvendar os segredos das células, impulsionar a engenharia de tecidos e liderar pesquisas antivirais para moldar o futuro da saúde global.
A equipe
Formada por uma equipe técnica exclusivamente feminina de diferentes especialidades e com Doutorado, , prezamos pela excelência científica e inovadora como forma de acelerar a inovação e o diferencial competitivo dos produtos que trabalhamos. Nossa atuação vai de encontro aos princípios de ESG com foco em substituir o uso de animais para pesquisa!
Vem conhecer mais da nossa equipe:

A Dra. Bibiana Matte é a fundadora da Núcleo Vitro. Conta com mais de 14 anos de experiência em pesquisa e se especializou na área de cultivo de células e engenharia de tecidos. Possui graduação e doutorado pela Universidade Federal do Rio Grande do Sul (UFRGS) e tem experiência de pesquisa na University of Michigan (EUA) e University of California San Diego (EUA). Desenvolve modelos inovadores, exclusivos e patenteados desde 2019 na Núcleo Vitro.

A Dra. Helouise Medeiros é biomédica e tem mestrado e doutorado em Ciências Médicas pela Universidade Federal do Rio Grande do Sul (UFRGS). Ampla experiência em cultivo de células e análises bioquímicas e coordena os estudos realizados na Núcleo Vitro.

A Vanessa Peixoto é química industrial e tem pós-graduação em Cosmetologia pela Faculdade Oswaldo Cruz. Atua a frente do comercial da Núcleo Vitro entendo os projetos, os claims de produtos e trazendo as soluções com base na tecnologia e inovação científica da cultura celular e engenharia tecidual.

A Dra. Melissa Tôrres é biomédica e tem mestrado em Biologia Celular e Molecular pela Pontifícia Universidade Católica do Rio Grande do Sul (PUCRS) e doutorado em Química Biológica pela Universidade Federal do Rio de Janeiro (UFRJ). Ampla experiência em cultivo de células e análises bioquímicas.
PREMIAÇÕES RECEBIDAS EM 2026
Mulheres Inovadoras, promovido pela FINEP

Prêmio Startup Mais Disruptiva do South Summit 2026

